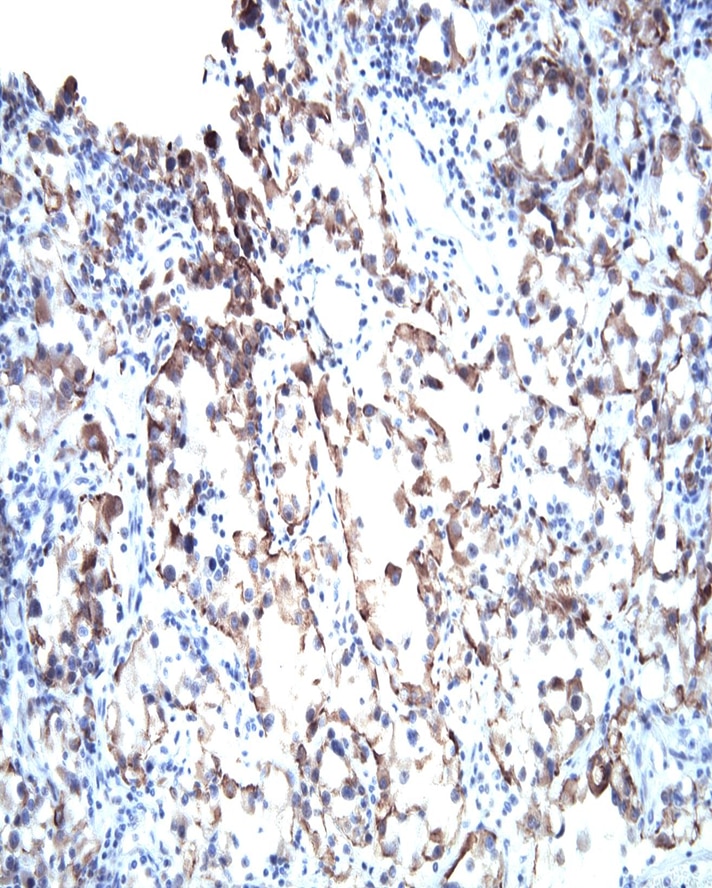

-
Reagents
- Flow Cytometry Reagents
-
Western Blotting and Molecular Reagents
- Immunoassay Reagents
-
Single-Cell Multiomics Reagents
- BD® OMICS-Guard Sample Preservation Buffer
- BD® AbSeq Assay
- BD® Single-Cell Multiplexing Kit
- BD Rhapsody™ ATAC-Seq Assays
- BD Rhapsody™ Whole Transcriptome Analysis (WTA) Amplification Kit
- BD Rhapsody™ TCR/BCR Next Multiomic Assays
- BD Rhapsody™ Targeted mRNA Kits
- BD Rhapsody™ Accessory Kits
- BD® OMICS-One Protein Panels
- BD OMICS-One™ WTA Next Assay
-
Functional Assays
-
Microscopy and Imaging Reagents
-
Cell Preparation and Separation Reagents
Old Browser
This page has been recently translated and is available in French now.
Looks like you're visiting us from {countryName}.
Would you like to stay on the current location site or be switched to your location?
BD Pharmingen™ Purified Mouse Anti-VHL
Clone Ig32 (RUO)

VHL Immunohistochemical staining on human renal cell carcinoma. Formalin fixed paraffin embedded human renal cell carcinoma was pretreated with BD Retrervagen A (Cat. No. 550524) and then stained with either Purified Mouse IgG1, κ isotype control (Clone MOPC-21; Left Panel) or Purified Mouse anti-VHL (Right Panel).

VHL Immunohistochemical staining on human renal cell carcinoma. Formalin fixed paraffin embedded human renal cell carcinoma was pretreated with BD Retrervagen A (Cat. No. 550524) and then stained with either Purified Mouse IgG1, κ isotype control (Clone MOPC-21; Left Panel) or Purified Mouse anti-VHL (Right Panel).



VHL Immunohistochemical staining on human renal cell carcinoma. Formalin fixed paraffin embedded human renal cell carcinoma was pretreated with BD Retrervagen A (Cat. No. 550524) and then stained with either Purified Mouse IgG1, κ isotype control (Clone MOPC-21; Left Panel) or Purified Mouse anti-VHL (Right Panel).
VHL Immunohistochemical staining on human renal cell carcinoma. Formalin fixed paraffin embedded human renal cell carcinoma was pretreated with BD Retrervagen A (Cat. No. 550524) and then stained with either Purified Mouse IgG1, κ isotype control (Clone MOPC-21; Left Panel) or Purified Mouse anti-VHL (Right Panel).

VHL Immunohistochemical staining on human renal cell carcinoma. Formalin fixed paraffin embedded human renal cell carcinoma was pretreated with BD Retrervagen A (Cat. No. 550524) and then stained with either Purified Mouse IgG1, κ isotype control (Clone MOPC-21; Left Panel) or Purified Mouse anti-VHL (Right Panel).

VHL Immunohistochemical staining on human renal cell carcinoma. Formalin fixed paraffin embedded human renal cell carcinoma was pretreated with BD Retrervagen A (Cat. No. 550524) and then stained with either Purified Mouse IgG1, κ isotype control (Clone MOPC-21; Left Panel) or Purified Mouse anti-VHL (Right Panel).

Regulatory Status Legend
Any use of products other than the permitted use without the express written authorization of Becton, Dickinson and Company is strictly prohibited.
Preparation And Storage
Recommended Assay Procedures
Western Blot: Clone Ig32 is not recommended for Western blot application. It has been shown to recognize a non-specific band above VHL protein. However, RNAi studies have demostrated that clone Ig32 recognizes a fainter band below this dominant band. Also, labs have reported using the 786-O renal cell adenocarcinoma cell line (ATCC CRL-1932, VHL null), siRNA or VHL overexpression to show that clone Ig32 recognizes the VHL protein specifically. Therefore, we recommend using clone Ig32 in over-expressing systems or under native (non-denaturing) conditions such as IHC staining or immunoprecipitation (IP) applications.
Immunohistochemistry: The Ig32 antibody is useful for immunohistochemical staining. Following Retrievagen A pretreatment, purified Ig32 antibody should be used at 2.5 µg/ml to 5 µg/ml and titrated for optimal indirect immunohistochemical staining. Tissues can be visualized via a three-step staining procedure in combination with Biotin Goat anti-Mouse Ig (Cat. No. 550337) secondary antibody and Streptravidin-HRP (Cat. No. 550946) together with the DAB Substrate Kit (Cat. No. 550880). More conveniently, the Anti-Mouse Ig HRP Detection Kit (Cat. No. 551011) that contains the biotinylated secondary antibody, antibody diluent, streptavidin-HRP and DAB substrate can be used for staining. For IHC staining on paraffin sections, please refer to http://www.bdbiosciences.com/documents/Immuno_Prep_Stain_Paraffin.pdf
Additional protocol information can be found at http://www.bdbiosciences.com/support/resources/cell_biology/index.jsp
IP: The purified Ig32 antibody has been reported to be useful to immunoprecipitate native human VHL. Please note that this application is not routinely tested at BD Biosciences Pharmingen. Investigators are advised to determine optimal concentrations for individual applications.
Product Notices
- Since applications vary, each investigator should titrate the reagent to obtain optimal results.
- Caution: Sodium azide yields highly toxic hydrazoic acid under acidic conditions. Dilute azide compounds in running water before discarding to avoid accumulation of potentially explosive deposits in plumbing.
- Please refer to www.bdbiosciences.com/us/s/resources for technical protocols.
The von Hippel-Lindau (VHL) protein is a tumor suppressor that is highly conserved from Drosophila to mammals. VHL protein normally associates with the transcription factor Elongin. Transcription factors typically act in one of three transcriptional stages, initiation, elongation or termination. Elongin functions by increasing the rate of elongation, the rate at which RNA subunits are added to make an RNA transcript longer. Elongin is made up of three subunits, A, B, and C, and each subunit contributes to the function of the whole protein. VHL binds to Elongin B and C subunits, and appears to prevent Elongin A from associating with the B and C subunits, thereby inhibiting the transcriptional activity of Elongin. The ability of VHL to block Elongin function may play a role in normal cell growth regulation. Mutated VHL sequences lose their ability to bind to Elongin subunits B and C, suggesting that the tumor suppression function of VHL may be linked to its ability to bind to Elongin. Likewise, the introduction of wild-type VHL suppresses growth in tumor cell lines lacking normal expression of VHL genes, further supporting a role for VHL in negative growth regulation. The calculated molecular weight of VHL is 24 kDa. However, different migrating species ranging from 21-30 kDa have been observed using antibodies to VHL, and may result from a variety of factors including alternatively spliced VHL mRNAs and protein degradation. This antibody has been reported to recognize both human and mouse VHL.
Development References (8)
-
Baba M, Hirai S, Kawakam S, et al. Tumor suppressor protein VHL is induced at high cell density and mediates contact inhibition of cell growth. Oncogene. 2001; 20(22):2727-2736. (Methodology: Immunoprecipitation). View Reference
-
Chen F, Kishida T, Duh FM, et al. Suppression of growth of renal carcinoma cells by the von Hippel-Lindau tumor suppressor gene. Cancer Res. 1995; 55(21):4804-4807. (Biology). View Reference
-
Hsu T, Adereth Y, Kose N, Dammai V. Endocytic function of von Hippel-Lindau tumor suppressor protein regulates surface localization of fibroblast growth factor receptor 1 and cell motility. J Biol Chem. 2006; 28(281):12069-12080. (Methodology: Induction). View Reference
-
Iliopoulos O, Kibel A, Gray S, Kaelin WG Jr. Tumour suppression by the human von Hippel-Lindau gene product.. Nat Med. 1995; 1(8):822-826. (Biology). View Reference
-
Iliopoulos O, Ohh M, Kaelin WG Jr.. pVHL19 is a biologically active product of the von Hippel-Lindau gene arising from internal translation initiation. Proc Natl Acad Sci U S A. 1998; 95(20):11661-11666. (Methodology: Immunoprecipitation). View Reference
-
In: Hesketh R. The Oncogene Handbook. New York: Academic Press; 1994:559.
-
Kibel A, Iliopoulos O, DeCaprio JA, Kaelin WG Jr. Binding of the von Hippel-Lindau tumor suppressor protein to Elongin B and C. Science. 1995; 269(5229):1444-1446. (Immunogen: Immunoprecipitation). View Reference
-
Qi H, Gervais ML, Li W, DeCaprio JA, Challis JR, Ohh M. Molecular cloning and characterization of the von Hippel-Lindau-like protein. Mol Cancer Res. 2004; 2(1):43-52. (Methodology: Immunoprecipitation). View Reference
Please refer to Support Documents for Quality Certificates
Global - Refer to manufacturer's instructions for use and related User Manuals and Technical data sheets before using this products as described
Comparisons, where applicable, are made against older BD Technology, manual methods or are general performance claims. Comparisons are not made against non-BD technologies, unless otherwise noted.
For Research Use Only. Not for use in diagnostic or therapeutic procedures.